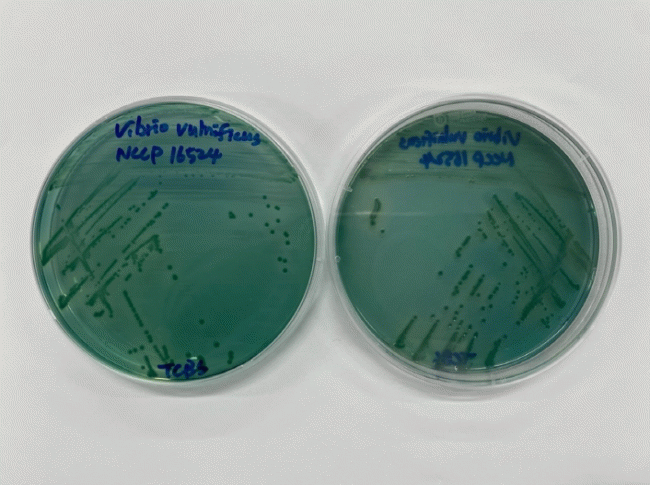

|
КёКъИЎПР ЦаЧїСѕРК ЧиМі ПТЕЕАЁ ЛѓНТЧЯДТ ПЉИЇУЖПЁ С§СпРћРИЗЮ ЙпЛ§ЧЯДТ АЈПАКДРИЗЮ, МЧиОШ СіПЊ ЧиМіПЭ АЙЙњ, ОюЦаЗљПЁМ СжЗЮ АЫУтЕШДй. ЦЏШї АЃ СњШЏРк, ИщПЊРњЧЯРк Ею АэРЇЧшБКРЬ АЈПАЕЩ АцПь ЦаЧїСѕРИЗЮ СјЧрЕХ ФЁЛчРВРЬ 50%ПЁ ДоЧЯДТ РЇЧшЧб СњКДРЬДй.
СіГЧи РќКЯ КИАЧШЏАцПЌБИПјРЬ МіЧрЧб 897АЧРЧ СЖЛчПЁМ КёКъИЎПР ЦаЧїСѕБеРЬ 3.12% АЫУтЕЦРИИч, ЦЏШї 2024ГтПЁДТ 4ПљПЁ УЙ АЫУт ЛчЗЪАЁ ШЎРЮЕХ 2023ГтКИДй 2СжАЁЗЎ КќИЃАд ГЊХИГЕДй. РЬПЁ ЕћЖѓ РќКЯРкФЁЕЕДТ ПУЧи 4ПљКЮХЭ ЧиОч АЈПАКД ШЎЛъРЛ ЙцСіЧЯБт РЇЧб МБСІРћ ДыРРПЁ ГЊМБДй.
КёКъИЎПР ЦаЧїСѕРЛ ПЙЙцЧЯЗСИщ ЁуОюЦаЗљДТ ЙнЕхНУ 85ЁЩ РЬЛѓПЁМ УцКаШї АЁП ШФ МЗУыЧЯАэ Ёу5ЁЩ РЬЧЯПЁМ РњПТ КИАќЧиОп ЧЯИч ЁуЧиМіПЁ МеРЬГЊ ЧЧКЮ ЛѓУГАЁ ДъСі ОЪЕЕЗЯ СжРЧЧиОп ЧбДй.
РќАцНФ РќКЯ КИАЧШЏАцПЌБИПјРхРК ЁАБтШФ ПТГШЗЮ ЧиОч ШЏАцРЬ КЏШЧЯИщМ КёКъИЎПРБеРЧ СѕНФ АЁДЩМКРЬ ДѕПэ ФПСіАэ РжДйЁБИч ЁАПЌБИПјРК СіМгРћРЮ АЈНУПЭ РЏЧр КаМЎРЛ ХыЧи АЈПАКД ЙпЛ§РЛ СЖБтПЁ РЮНФЧЯАэ, НХМгЧб ДыРРРИЗЮ ШЎЛъРЛ ИЗРЛ Мі РжЕЕЗЯ УжМБРЛ ДйЧЯАкДйЁБАэ АСЖЧпДй.
РЬПЌШ БтРк
 2026.02.05(Иё) 23:13
2026.02.05(Иё) 23:13